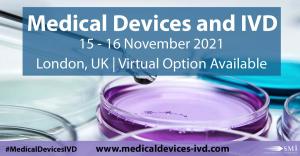

Registration is now open for Medical Devices and IVD Conference 2021
SMi Group reports: The agenda for the launch of Medical Devices and IVD Conference 2021 which will convene on 15th and 16th November has been released.
LONDON, ENGLAND, UNITED KINGDOM, June 8, 2021 /EINPresswire.com/ -- SMi Group is proud to announce the launch of their Medical Devices and IVD Conference which will commence on 15th and 16th November 2021. This upcoming conference will explore into the latest updates in EU MDR and IVDR regulations as well as strategies for how to best comply with these new regulations and consider the evolving regulatory landscape for digital health software.Registration for this event is now open and interested parties can register at www.medicaldevices-ivd.com/einPR1 - register by 30th June to save £200 with the early bird offer.
The MDR and IVDR updates will have a profound impact on the medical device industry, bringing certain products into regulatory scope that were previously excluded, introducing new manufacturing requirements, and increasing the burden for post-market surveillance.
What does this mean for the future of Medical Devices and IVD industry? Find out from expert industry speakers:
• Jessica Wilkerson, Cyber Policy Advisor, FDA
• Susan Neadle, Executive Director, Combination Products, Devices, Diagnostics & Digital Health Regulatory Affairs, Amgen
• Claudia Dollins, Head, Precision Medicine & Companion Diagnostics, Bristol Myers Squibb
• Michael Benecky, Senior Director, Global Regulatory Affairs, UCB Biosciences
• Christophe Driesmans, Head of the Materiovigilance Entity, Federal Agency for Medicines and Health Products (FAMHP)
• Melanie Donguy, Head Regulatory Affairs EMEA, Bayer Radiology
• Marc Moal, Head of Product Delivery & Project Management, Merck Connected Health & Devices
• Jim Leamon, Director of Biologics Device Development, Jazz Pharmaceuticals
• Louise Place, Director, Devices, GlaxoSmithkline
• Stefan Strasser, Head of Department, Austrian Medicines and Medical Devices Agency
An interactive half-day post – conference workshop will also convene on 17th November 2021, led by Blake Green, Senior Manager Regulatory Affairs, Amgen speaking on “Implementing the EU MDR and Article 117, An Industry Perspective”.
Join Europe’s leading Medical Device and IVD Conference which will address post-market surveillance and vigilance, clinical evaluations and investigations, medical device regulatory affairs in global markets, and much more. The event brochure with the agenda and speaker line-up is available from the website; those interested in attending can register at: at www.medicaldevices-ivd.com/einPR1
Medical Devices and IVD
15th – 16th November 2021
London, UK
#MedicalDevicesIVD
Half – Day Post Conference Workshop: 17th November 2021
SMi offer sponsorship, exhibition, advertising and branding packages, uniquely tailored to
compliment you company’s marketing strategy, For more details and all delegate enquiries please contact Alia Malick, Director on +44 (0) 20 7827 6168. For media queries please contact Jinna Sidhu at hsidhu@smi-online.co.uk or call +44 (0)20 7827 6088.
--END--
About SMi Group:
Established since 1993, the SMi Group is a global event-production company that specializes in Business-to-Business Conferences, Workshops, Masterclasses and online Communities. We create and deliver events in the Defence, Security, Energy, Utilities, Finance and Pharmaceutical industries. We pride ourselves on having access to the world’s most forward-thinking opinion leaders and visionaries, allowing us to bring our communities together to Learn, Engage, Share and Network. More information can be found at http://www.smi-online.co.uk
Jinna Sidhu
SMi Group
+442078276088 ext.
email us here
Visit us on social media:
Twitter
LinkedIn
Legal Disclaimer:
EIN Presswire provides this news content "as is" without warranty of any kind. We do not accept any responsibility or liability for the accuracy, content, images, videos, licenses, completeness, legality, or reliability of the information contained in this article. If you have any complaints or copyright issues related to this article, kindly contact the author above.